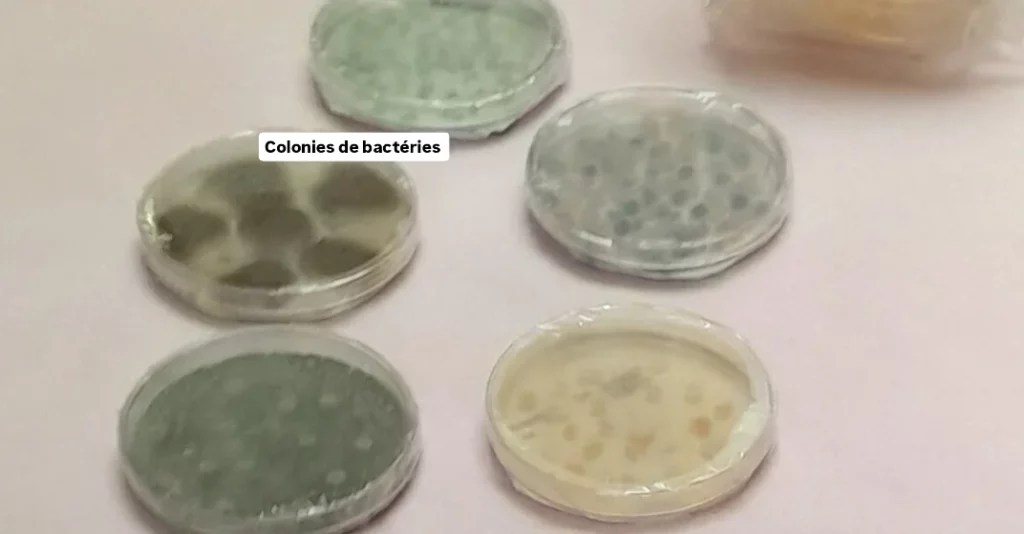

fête de la science

La classe du Lycée inversé à eu la chance de participer à la fête de la science sur le campus Jussieu. Animés par des étudiants et des professeurs, jeu de société, observation, microscope, boîte de pétri…sur le thème Microbe et corps humain!